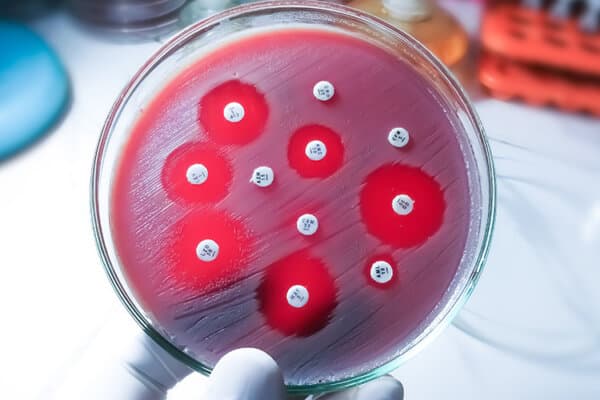

Prophylaxie des infections urinaires
Lors d’un séminaire de formation continue organisé par Tribune Médicale sur les cystites*, il a été notamment été question de la prévention des infections urinaires récidivantes. Globalement, il s’avère que même si on peut affirmer que de nombreux chemins mènent à Rome, il n’en demeure pas moins que toutes les approches ne sont pas suffisamment étayées par des études.
Jusqu’à 40 à 50 % des femmes font une infection urinaire au moins une fois dans leur vie, et jusqu’à 10 % ont des infections récidivantes.
Les infections urinaires récidivantes (IUR) sont définies comme deux infections ou plus documentées en l’espace de six mois ou trois infections ou plus par an, a expliqué le Pr Gernot Bonkat, alta uro AG, Bâle, et président du comité des lignes directrices sur les infections urologiques de l’Association européenne d’urologie (EAU).
- Hayward G et al. d-Mannose for Prevention of Recurrent Urinary Tract Infection Among Women: A Randomized Clinical Trial. JAMA Intern Med. 2024 Jun 1;184(6):619-628. doi: 10.1001/jamainternmed.2024.0264
- Lee BS et al. Methenamine hippurate for preventing urinary tract infections. Cochrane Database Syst Rev. 2012 Oct 17;10(10):CD003265. doi: 10.1002/14651858.CD003265.pub3
- Bakhit M et al. Use of methenamine hippurate to prevent urinary tract infections in community adult women: a systematic review and meta-analysis. Br J Gen Pract. 2021 Jun 24;71(708):e528-e537. doi: 10.3399/BJGP.2020.0833
- Harding Cet al. Alternative to prophylactic antibiotics for the treatment of recurrent urinary tract infections in women: multicentre, open label, randomised, non-inferiority trial. BMJ. 2022 Mar 9;376:e068229. doi: 10.1136/bmj-2021-0068229
- Naber KG et al. Immunoactive prophylaxis of recurrent urinary tract infections: a meta-analysis. Int J Antimicrob Agents. 2009 Feb;33(2):111-9. doi: 10.1016/j.ijantimicag.2008.08.011
